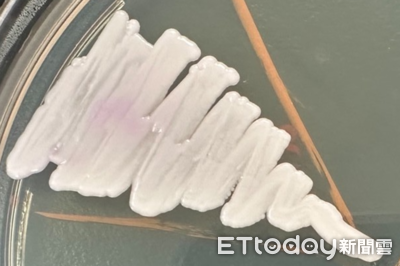
耳念珠菌被稱為「超級真菌」　醫：抗藥性強、酒精殺不死

耳念珠菌被稱為「超級真菌」 醫:抗藥性強、酒精殺不死

耳念珠菌被外媒稱為「超級真菌」,相關感染在國際深受矚目,國內也出現新增個案。專家指出,這類感染多半集中在醫療院所,但因跨國往來持續增加,「台灣不可能永遠沒事」,一旦警覺不足或感染管制鬆動,仍可能出現風險。 《詳全文...》
耳念珠菌被外媒稱為「超級真菌」,相關感染在國際深受矚目,國內也出現新增個案。專家指出,這類感染多半集中在醫療院所,但因跨國往來持續增加,「台灣不可能永遠沒事」,一旦警覺不足或感染管制鬆動,仍可能出現風險。 《詳全文...》